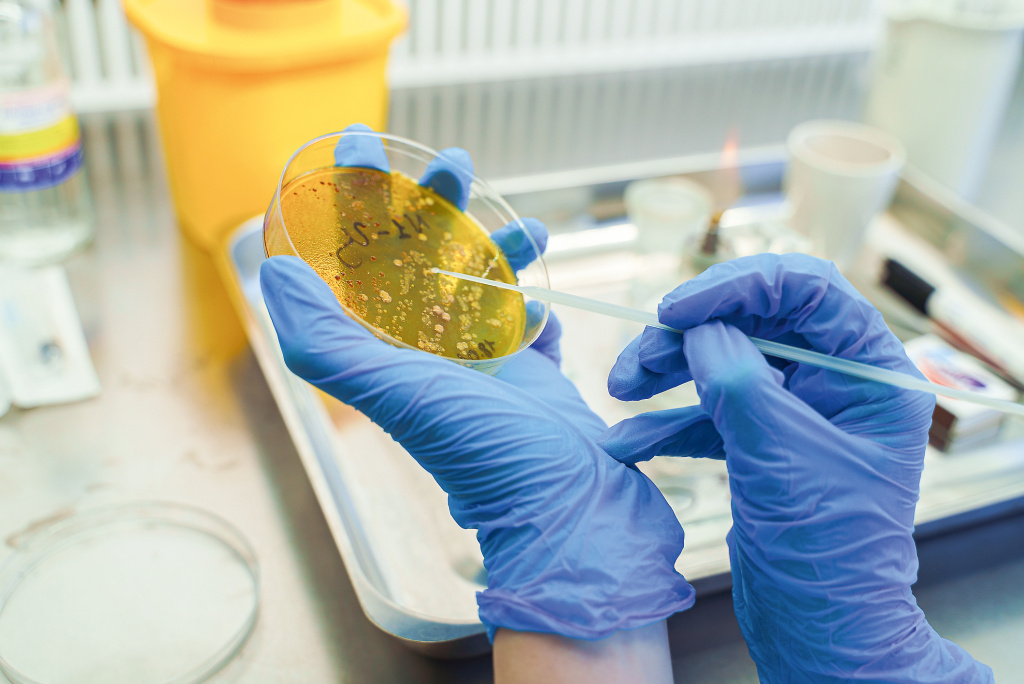
Медколледж-№-1-(9).jpg

Команда корреспондентов газеты «Московская медицина. Cito» накануне Дня студентов посетила несколько медицинских колледжей Департамента здравоохранения города Москвы и собственными глазами увидела, как взращиваются будущие медсёстры, фельдшеры и лаборанты.
Всего в столице пять медицинских колледжей, а также Свято-Димитриевское училище сестёр милосердия. Учредителем этих образовательных организаций является Департамент здравоохранения города Москвы. Обучение в медицинских колледжах проходят более 12 000 студентов по шести специальностям: «сестринское дело», «лечебное дело», «лабораторная диагностика», «акушерское дело», «стоматология ортопедическая» и «медицинский массаж» (для лиц с ограниченными возможностями здоровья по зрению).

Отработка «плевральной пункции». Фото: Пётр Фёдоров/НИИОЗММ
Ученье – свет. И практики тьма
Уже с первого семестра у студентов медколледжей начинается практика. На такие занятия выделяется около 70 % от программы профессиональной подготовки. Опытом с ребятами делятся сотрудники столичных поликлиник, крупнейших стационаров и флагманских центров.
Прежде чем студенты приступят к практике в медицинских организациях, они отрабатывают все необходимые навыки на современных тренажёрах, фантомах и манекенах, которые имитируют тело человека (его рост, вес, кожу), воссоздают симптомы заболеваний.
Например, Медицинский колледж № 7 полностью оснащён необходимым симуляционным оборудованием для того, чтобы ребята в совершенстве освоили специальности «лечебное дело» и «сестринское дело». С первого курса они пользуются интерактивным анатомическим столом «Пирогов», который доступен не только на занятиях, но и через мобильное приложение. Далее студенты не просто обучаются работе с современной медицинской аппаратурой, но и оттачивают физикальные навыки – осмотр пациента с целью постановки диагноза при помощи органов чувств врача. Ребята обучаются проведению комплекса сердечно-лёгочной реанимации и работе с травматологическими пациентами. Для этого разыгрываются различные сценарии: бытовые несчастные случаи, автомобильные аварии с пострадавшими. Студенты должны провести быстрый анализ ситуации, правильно отсортировать пациентов по приоритету оказания медицинской помощи и применить все свои знания для спасения жизней.
Проведение лабораторных опытов. Фото: Руслан Игамбердиев/НИИОЗММ
«Такие ситуации, с которыми регулярно сталкиваются фельдшеры на практике, отрабатываются малыми группами по три-четыре человека в специальном кабинете на манекенах», – рассказал заведующий структурным подразделением «Лечебное дело» Медицинского колледжа № 7 Валерий Евтушенко.
Один из важных тренажёров для студентов старших курсов – это тренажёрный комплекс «Макет автомобиля скорой медицинской помощи», который появился в колледже около четырёх лет назад.
«Когда мы приобретали эту машину, советовались по наполнению и правильному расположению всего оборудования с экспертами Станции скорой и неотложной медицинской помощи имени А. С. Пучкова», – комментирует директор Медицинского колледжа № 7 Елена Бояр.
Тренажёр умеет имитировать движение машины в городских условиях и по бездорожью. Это помогает отточить действия в любых обстоятельствах. Интерактивный манекен, выступающий в роли пациента, передаёт сигналы на приборы. Задаётся ситуация, в которой у больного развиваются острый инфаркт, отёк легких и сердечная недостаточность. Три студента берутся за дело: пациента необходимо интубировать, вместе с этим контролировать показатели электрокардиограммы, гемодинамику и вводить необходимые препараты.

Тренажёр, имитирующий реальную машину скорой помощи. Фото: Пётр Фёдоров/НИИОЗММ
«Если на приборах появляются данные, говорящие об остановке сердца у пациента, то ребята должны мгновенно переключиться на реанимационные действия. Мы можем моделировать любую историю: есть манекен, на котором можно отработать принятие родов в машине скорой помощи, есть детские манекены», – рассказала преподаватель хирургии, кандидат медицинских наук Ирина Гагаева.
Также во время обучения студенты знакомятся с цифровыми сервисами, которые используются столичными фельдшерами и работниками городских поликлиник. Единую медицинскую
информационно-аналитическую систему (ЕМИАС) осваивают в специальных кабинетах, а Автоматизированную навигационно-диспетчерскую систему управления (АНДСУ) – во время практики с выездными бригадами фельдшеров.

Система для подъёма и переноса тяжелобольных. Фото: Пётр Фёдоров/НИИОЗММ
В Медицинском колледже № 2 уже более 30 лет готовят специалистов для системы столичного здравоохранения. Сотрудники первыми из всех образовательных учреждений организовали маркировку расходных материалов. У каждого преподавателя есть тематический план занятий по специальностям «лечебное дело» и «сестринское дело», где определены манипуляции, которые студенты должны будут демонстрировать. И маркировка расходников упрощает подготовку к практике.
Для решения клинических и ситуационных задач в колледже есть различные интерактивные симуляторы, такие как система «Виртуальный пациент-К» (с модулями «Боткин» и «Филатов») и образовательная программа МедМан.
С 2023 года медицинские учреждения перешли на практико-ориентированные образовательные программы, и Медицинский колледж № 2 не исключение. «Сейчас процент практических занятий увеличен. Теоретические блоки сокращены максимально возможно для того, чтобы ребята на выходе имели поставленную руку и набор компетенций, необходимых для трудоустройства в медицинские организации. Это регламентируется новым государственным образовательным стандартом. Теперь обучающиеся отправляются на производственную практику намного раньше: если ребята, поступавшие к нам до 2023 года, первый год изучали общеобразовательные дисциплины, в этом году уже с первого семестра они выходят на базы медицинских организаций. Конечно, студенты довольны: после девяти классов они быстро погружаются в систему здравоохранения ввиду того, что срок обучения сокращается на год. Эта программа для нас является ноу-хау», – рассказала директор Медицинского колледжа № 2 Ольга Аликперова.
Для того чтобы студенты могли повторять информацию в любой момент и не забывали верную технику выполнения манипуляций, сотрудниками были сняты видеоматериалы по всей программе учебных курсов. Предусмотрено и обучение навыкам работы с ЕМИАС: с 2023 года в программу внедрён новый модуль «Ведение медицинской документации». В стенах колледжа предусмотрено всё, чтобы студенты выходили на практику хорошо подготовленными. В одном из помещений смонтирована потолочная рельсовая система для подъёма и переноса тяжелобольных и маломобильных пациентов. Конструкция используется как для гигиенических процедур: ванн, обработки пролежней, смены постельного белья, так и для проведения различных исследований, например МРТ, КТ. Рельсовая система даёт возможность поднимать до 400 килограммов (некоторые модели рассчитаны на вес в 500 килограммов). Навык работы с этой системой студенты получают уже с первого курса. Полученные знания и умения помогают подготовиться к работе в паллиативной службе или в отделениях онкологических больниц.
«Это оборудование – огромное подспорье для каждого из нас, потому что благодаря ему мы можем отработать все навыки не только на базах практики, но и в своём собственном колледже», – рассказала студентка Медицинского колледжа № 2 Ксения.

Студентка работает с биологическими материалами и реактивами. Фото: Руслан Игамбердиев/НИИОЗММ
Молодые исследователи
Медицинский колледж № 1 – один из крупнейших в столице. Уже более 70 лет он осуществляет подготовку специалистов среднего медицинского образования по востребованным профессиям в медицинских организациях города. Обучение проводится по трём специальностям: «сестринское дело», «лабораторная диагностика» и «лечебное дело».
В корпусе на Ивантеевской улице ведётся по подготовка специалистов лабораторной службы – «медицинских лабораторных техников».
«Ежегодно к нам поступают порядка 150–200 человек. Приём осуществляется на базе 9-х и 11-х классов. После окончания обучения наши выпускники устраиваются на работу в клинико-диагностические лаборатории города. Помимо базового образования, наши студенты также получают дипломы профессиональной переподготовки на выбор по двум направлениям – бактериология или гистология. Это позволяет им без потери времени трудоустроиться именно в ту лабораторию, которая им более интересна в профессиональном плане», – рассказала директор Медицинского колледжа № 1 Анжела Геккиева.
Студенты изучают семь основных профессиональных модулей (общая клиника, биохимия, микробиология, гематология и др.). Занятия проходят в условиях, максимально приближенных к действующим лабораториям. Кабинеты оснащены современным оборудованием (анализаторы, микроскопы и др.), часть из которого перераспределена из действующих медицинских организаций.

Подготовка пробы к анализу. Фото: Руслан Игамбердиев/НИИОЗММ
«Отдельный блок составляет производственная практика. Она проходит на базе крупнейших стационаров, поликлиник и других медицинских организаций. Каждый студент прикрепляется к наставнику из числа опытных сотрудников лабораторий. Такой подход позволяет нашим студентам максимально близко познакомиться с будущей профессией, получить необходимые навыки и умения для дальнейшей самостоятельной работы», – подчеркнула Анжела Геккиева.
Студенты колледжа также постоянно посещают конгрессы, конференции и форумы. Это прекрасная возможность не только узнать что-то новое, но и поделиться своими достижениями. Осенью прошлого года члены студенческого научного кружка «Качество лабораторных исследований» выступили с докладом на IX Российском конгрессе лабораторной медицины. Это был первый подобный опыт, и он оказался весьма успешным. Ребята планируют и дальше развиваться в этом направлении.
«За время учёбы в колледже я получила все необходимые навыки и умения, которые потребуются для дальнейшей работы. Когда я поступала сюда, то не предполагала, что наша профессия насколько увлекательная и глубокая. Для себя я твёрдо решила, что буду развиваться в этой сфере и работать в лаборатории. Те знания, которые мы получили в колледже, позволяют быть востребованным специалистом в клинических лабораториях разного профиля», – говорит студентка 4-го курса Карина.
Все ребята из столичных медицинских колледжей, успешно сдавшие выпускные экзамены, получают диплом о среднем профессиональном образовании. Благодаря полученным знаниям и твёрдым навыкам молодые специалисты конкурентоспособны и востребованы среди столичных работодателей.
Евгения Воробьева, Надежда Владимирова, Ирина Степанова

